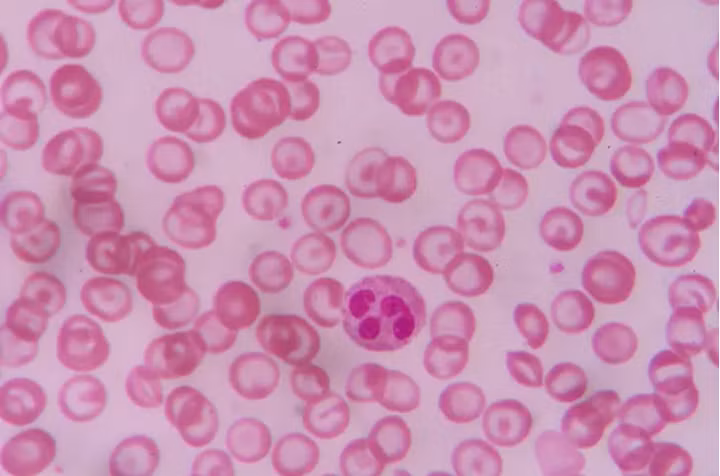
20

1. Dự đoán được 2040 sẽ có một cuộc khủng hoảng về biến đổi khí hậu

Một nghiên cứu do Liên Hợp Quốc thực hiện bởi 91 nhà khoa học từ 40 quốc gia đã phát hiện ra rằng nếu phát thải nhà kính tiếp tục duy trì ở mức hiện tại thì đến năm 2040, nhiệt độ Trái Đất sẽ tăng thêm 2.7 độ F, gây thiệt hại lên tới 54 nghìn tỷ USD.
Trước đây, ngưỡng hậu quả nghiêm trọng nhất của hiện tượng ấm lên toàn cầu là chỉ hơn 3.6 độ C một chút.
2. Cơ thể chúng ta có một cơ quan mới với tên gọi "interstitium"

Bạn có biết những lớp mô liên kết thật ra lại là một cơ quan của chính nó, chịu trách nhiệm di chuyển chất lỏng khắp cơ thể? Cơ quan mới được phát hiện này là một trong những cơ quan lớn nhất của cơ thể người, có ý nghĩa toàn diện, từ cách tế bào ung thư lan rộng cho đến mức độ hiệu quả của châm cứu.
3. Sau hàng năm trời bị bác bỏ, câu chuyện về "người sống sót trên con tàu nô lệ cuối cùng" đã được xuất bản

Năm 1931, Zora Neale Hurston từng cố gắng xuất bản Barracoon, câu chuyện về Kossuala, hay Cudjo Lewis, một người đàn ông bị bắt cóc làm nô lệ, mặc dù trong thực tế buôn bán nô lệ quốc tế đã được đặt ra ngoài vòng pháp luật
. Từng không có nhà xuất bản nào chấp nhận câu chuyện này, cho tới hồi tháng Năm năm nay, truyện được xuất bản bởi HerperCollins.
4. Hồ nước khổng lồ dưới lòng đất Sao Hỏa đã kết thúc cuộc tranh luận kéo dài hàng thập kỷ giữa các nhà thiên văn học

Các nhà khoa học từng nghi ngờ có tồn tại nước dạng lỏng trên Sao Hỏa trong một khoảng thời gian, nhưng sự nghi ngờ đó đến nay đã có thể kết thúc, khi thiết bị radar MARSIS phát hiện ra một hồ nước lỏng dài 12 dặm dưới bề mặt hành tinh này.
Trên Trái Đất, các khối nước lòng đất có thể chứa vi sinh vật liên quan đến các giống loài cổ đại. Các nhà khoa học đang chờ đợi xem điều tự có thể xảy ra trên Sao Hỏa hay không.
5. Bé gái 8 tuổi tìm thấy thanh gươm cổ 1.500 năm tuổi dưới đáy hồ ở Thụy Điển

Có lẽ chúng ta đã tìm ra người cai trị mới ở Saga Vanecek, người đã rút được thanh gươm nghìn năm tuổi, có thể xuất hiện từ thế kỷ thứ 5 hoặc thứ 6 sau Công Nguyên.
Cô bé tìm thấy thanh gươm khi đang chơi ở hồ Vidöstern. Ban đầu, nó được cho là một thanh kiếm của người Viking, nhưng đến nay, nó được xác định là có trước cả người Viking.
6. Giải pháp cho việc tái tạo nang tóc có thể được tìm thấy trong dầu chiên của McDonald

Một hóa chất được thêm vào dầu ăn của McDonald có tên dimethylpolysiloxane, có thể khuyến khích vi trùng nang lông (HFGs) phát triển trong môi trường phòng thí nghiệm.
Hiện tại, các nhà nghiên cứu chỉ có thể phát triển khoảng 50 HFG cùng một lúc, nhưng với dimethylpolysiloxane, họ có thể sản xuất lên tới 5.000 HFG. Những nang này hiện đã được cấy thành công trên chuột, nhưng vẫn còn phải tiếp tục theo dõi khi nhân rộng trên cơ thể người.
7. Nguyên vẹn cả một thành phố mất tích khi xưa đã được tìm thấy

Thành phố Tenea là nơi định cư của các tù nhân trong cuộc chiến thành Troia, sự tồn tại thành phố từng được các nhà khảo cổ hoài nghi. Nhưng nay, nhóm của Elena Korka và các đồng sự đã tìm ra một nơi như vậy, sau nhiều nỗ lực từ năm 2013, chứng minh rằng con người thật sự đã từng sinh sống tại đây.
8. Tìm thấy hàng tỷ tấn vi khuẩn "zombie" dưới bề mặt Trái đất, xác định lại định nghĩa của sự sống.

Hệ sinh thái được ước tính lớn hơn hàng trăm lần so với toàn bộ cuộc sống của con người và có thể tồn tại trong thời gian "gần địa chất" mà không cần đến ánh sáng mặt trời hay nước.
9. Tìm thấy một bản mô tả cực hiếm về Chúa Jesu cùng mái tóc ngắn

Bức chân dung này có thể là cảnh tượng tượng trưng đầu tiên của Chúa trong lễ rửa tội tại Thánh địa. Không có nhiều hình ảnh về Kito giáo, một phần có thể do quy định về các biểu tượng thờ cúng.
10. Lần đầu tiên nhân bản vô tính khỉ

Các nhà khoa học Trung Quốc đã sử dụng phương pháp từng nhân bản cừu Dolly để nhân bản một con khỉ vẹt vào hồi tháng 1. Đây là lần đầu tiên nhân bản vô tính trên một loài gần với con người thành công. Cặp khỉ được đặt tên là Zhong Zhong và Hua Hua, theo tiếng Trung, Zhonghua có nghĩa là "người Trung Quốc".
11. Tìm ra loài khủng long mới

Một hóa thạch khủng long đã được phát hiện vào năm 2012 tại Nam Phi, nhờ đó, vừa qua, các nhà khoa học đã có thể tái tạo lại được 26.000 họ hàng của loài brontosaurus. Tên của nó là Ledumahadi mafube, trong tiếng Haiti (ngôn ngữ chính thức của Nam Phi), có nghĩa là "tiếng sét khổng lồ khi chạng vạng".
12. Chương trình nghiên cứu sinh đôi của NASA cho thấy không gian vũ trụ làm thay đổi biểu hiện gen trong các phi hành gia sinh đôi

Các nhà khoa học tại NASA đã gửi phi hành gia Scott Kelly lên vũ trụ trong khi để người anh em sinh đôi là Mark ở lại Trái Đất. Do điều kiện môi trường áp lực, phần lớn biểu hiện gen của Scott Kelly đã thay đổi khi ở ngoài không gian trước khi trở lại trạng thái bình thường.
Tuy nhiên, 7% gen của anh có liên quan đến "hệ thống miễn dịch, sửa chữa DNA, tạo xương và hơn thế" vẫn chưa trở lại bình thường. NASA gọi những gen này là "gen không gian".
13. Cuối cùng chúng ta cũng đã xác định được loài sinh vật bí ẩn bất chấp toàn bộ các quy tắc cổ điển
Sinh vật kỳ lạ có tên Dickinsonia được cho là sinh vật lâu đời nhất được con người biết đến, có niên đại khoảng 558 triệu năm trước. Các nhà khoa học từng bối rối khi phát hiện ra nó thiếu mất một số đặc điểm của một loài động vật, họ từng cho rằng nó có thể là một loại amip khổng lồ hoặc là một thử nghiệm thất bại của tiến trình tiến hóa.
Tuy nhiên, những hóa thạch được khai quật gần đây với các lớp màng sinh học được bảo tồn đã xác nhận rằng, Dickinsonia thật sự là loài động vật được biết đến sớm nhất trên thế giới cho tới thời điểm hiện tại.
14. Rùa không phải lúc nào cũng có mai

Hóa thạch rùa 227 triệu năm tuổi được phát hiện gần đây trông hơi khác so với loài rùa hiện đại. Cụ rùa này dài 6 feet và có "thân hình kỳ lạ như một chiếc đĩa", nhưng không hề có mai.
Các hóa thạch rùa khác từng được biết đến cho thấy phần mai có khi được hình thành một phần, hoặc tồn tại một cách không bình thường cho lắm, các nhà khoa học từng lấy làm khó hiểu vì điều này.
Tuy nhiên, phát hiện rùa không mai gần đây đã giúp giải thích quá trình hình thành rùa hiện đại ra sao.
15. Thuốc tránh thai an toàn dành cho nam giới lần đầu được phát triển

Hầu hết các loại thuốc tránh thai cho nam giới trước đây đều đi kèm tác dụng phụ nghiêm trọng, hoặc luôn cần phải uống gấp đôi liều lượng trong ngày để đạt hiệu quả.
Nhưng nay, một thử nghiệm lâm sàng cho thấy chất dimethandrolone undecanoate hoặc DMAU có thể giảm testosterone một cách hiệu quả mà không gây ra tác dụng phụ đáng kể. Các thử nghiệm này cũng được sử dụng để phát triển một loại gel ngừa thai khác.
16. Phát hiện ra vật thể sáng nhất trong vũ trụ từ trước đến nay

Đó là một quasar (chuẩn tinh), có tên chính thức là PSO J352.4034-15.3373, cách chúng ta khoảng 13 tỷ năm ánh sáng. Điều đó có nghĩa là, những gì các nhà khoa học quan sát được từ nó ngày nay giống như lúc thời điểm hành thành vũ trụ ban đầu.
Thật ra thì vẫn có thể có một vật thể sáng hơn nằm đâu đó ngoài kia mà chúng ta chưa thấy. Tuy nhiên, với khoảng cách hiện tại, PSO J352.4034-15.3373 đang được coi là vật thể sáng nhất trong vũ trụ của chúng ta.
17. Cá mặt trăng thật ra là một loài máu nóng

Loài cá thường được cho là loài máu lạnh, thế nhưng mọi chuyện thay đổi vào mùa xuân năm nay, khi các nhà khoa học của NOAA phát hiện ra rằng opah (hay moonfish – cá mặt trăng) duy trì nhiệt độ cơ thể bằng cách liên tục vỗ vây.
Trong khi những "người hàng xóm" máu lạnh dưới đáy đại dương thường di chuyển chậm chạp, opah lại có thể "đuổi theo con mồi nhanh nhẹn như mực và di chuyển được quãng đường khá dài".
18. Phát hiện ra xưởng sản xuất bia cổ nhất trong một hang động tại Israel

Dấu vết khảo cổ học về bia được tìm thấy có niên đại 13.000 năm tuổi và thuộc về người Natufian, một nhóm thợ rèn bán định cư mà các nhà khoa học tin rằng, bia được sử dụng như một mối liên kết quan trọng giữa những người săn bắt hái lượm và các cộng đồng nông nghiệp đầu tiên.
Dư lượng bia được tìm thấy bởi các nhà nghiên cứu có trước bánh mì Natufian, điều đó cho thấy sự tin tưởng vào lý thuyết cho rằng con người thời kỳ đầu canh tác là nhằm sản xuất ra các sản phẩm chứa cồn hơn là bánh mỳ.
19. Đã có thể đảo ngược các tổn thương do bệnh Alzheimer gây ra trong tế bào não người

Các nhà nghiên cứu của Viện Gladstone tại California đã có thể đảo ngược tổn thương trong tế bào não người bằng cách chỉnh sửa gene apoE4, yếu tố nguy cơ di truyền chính của bệnh Alzheimer, thành một dạng vô hại của chính nó bằng phương pháp tế bào gốc.
Hầu hết các nghiên cứu thử nghiệm đã thành công trên chuột và đang có những phát hiện hiếm hoi khi chuyển sang áp dụng trên tế bào não người.
20. Người Canada trưởng thành đầu tiên được ghép tế bào gốc được cho là không có hồng cầu hình liềm
Revée Agyepong, 26 tuổi, đã nhận được tế bào gốc từ chị gái vào tháng 11 năm 2017. Vài tháng sau, vào tháng 4 năm 2018, các bác sĩ đã phát hiện gần như không có huyết sắc tố hồng cầu hình liềm trong máu của cô.
Trên hết là, trong khi hầu hết các bác sĩ thường đặc biệt ưu tiên để ghép chính xác giữa bệnh nhân được nhận và người hiến tặng tế bào gốc thì, các bác sĩ tại Đại học Illinois gần đây đã tìm ra một phương pháp cho phép "khớp một nửa" khi hiến tặng tế bào.
21. Đảo ngược thành công quá trình lão hóa trên chuột, mở ra khả năng thực hiện điều tương tự trên cơ thể người

Trước đây, các nghiên cứu thường điều khiển quá trình lão hóa trên chuột bằng cách can thiệp vào DNA, điều mà chúng ta không thể làm tương tự đối với người.
Nhưng nay, một nhóm các nhà nghiên cứu đã tìm ra được một loại hợp chất hóa học có ảnh hưởng tới gen, chịu trách nhiệm cho sự lão hóa ở các mạch máu. Hợp chất này, khi phát triển trên chuột, đã tăng tuổi thọ của chúng thêm 2 tháng. Hãy chờ xem điều này có thể ảnh hưởng tới con người hay không.





































